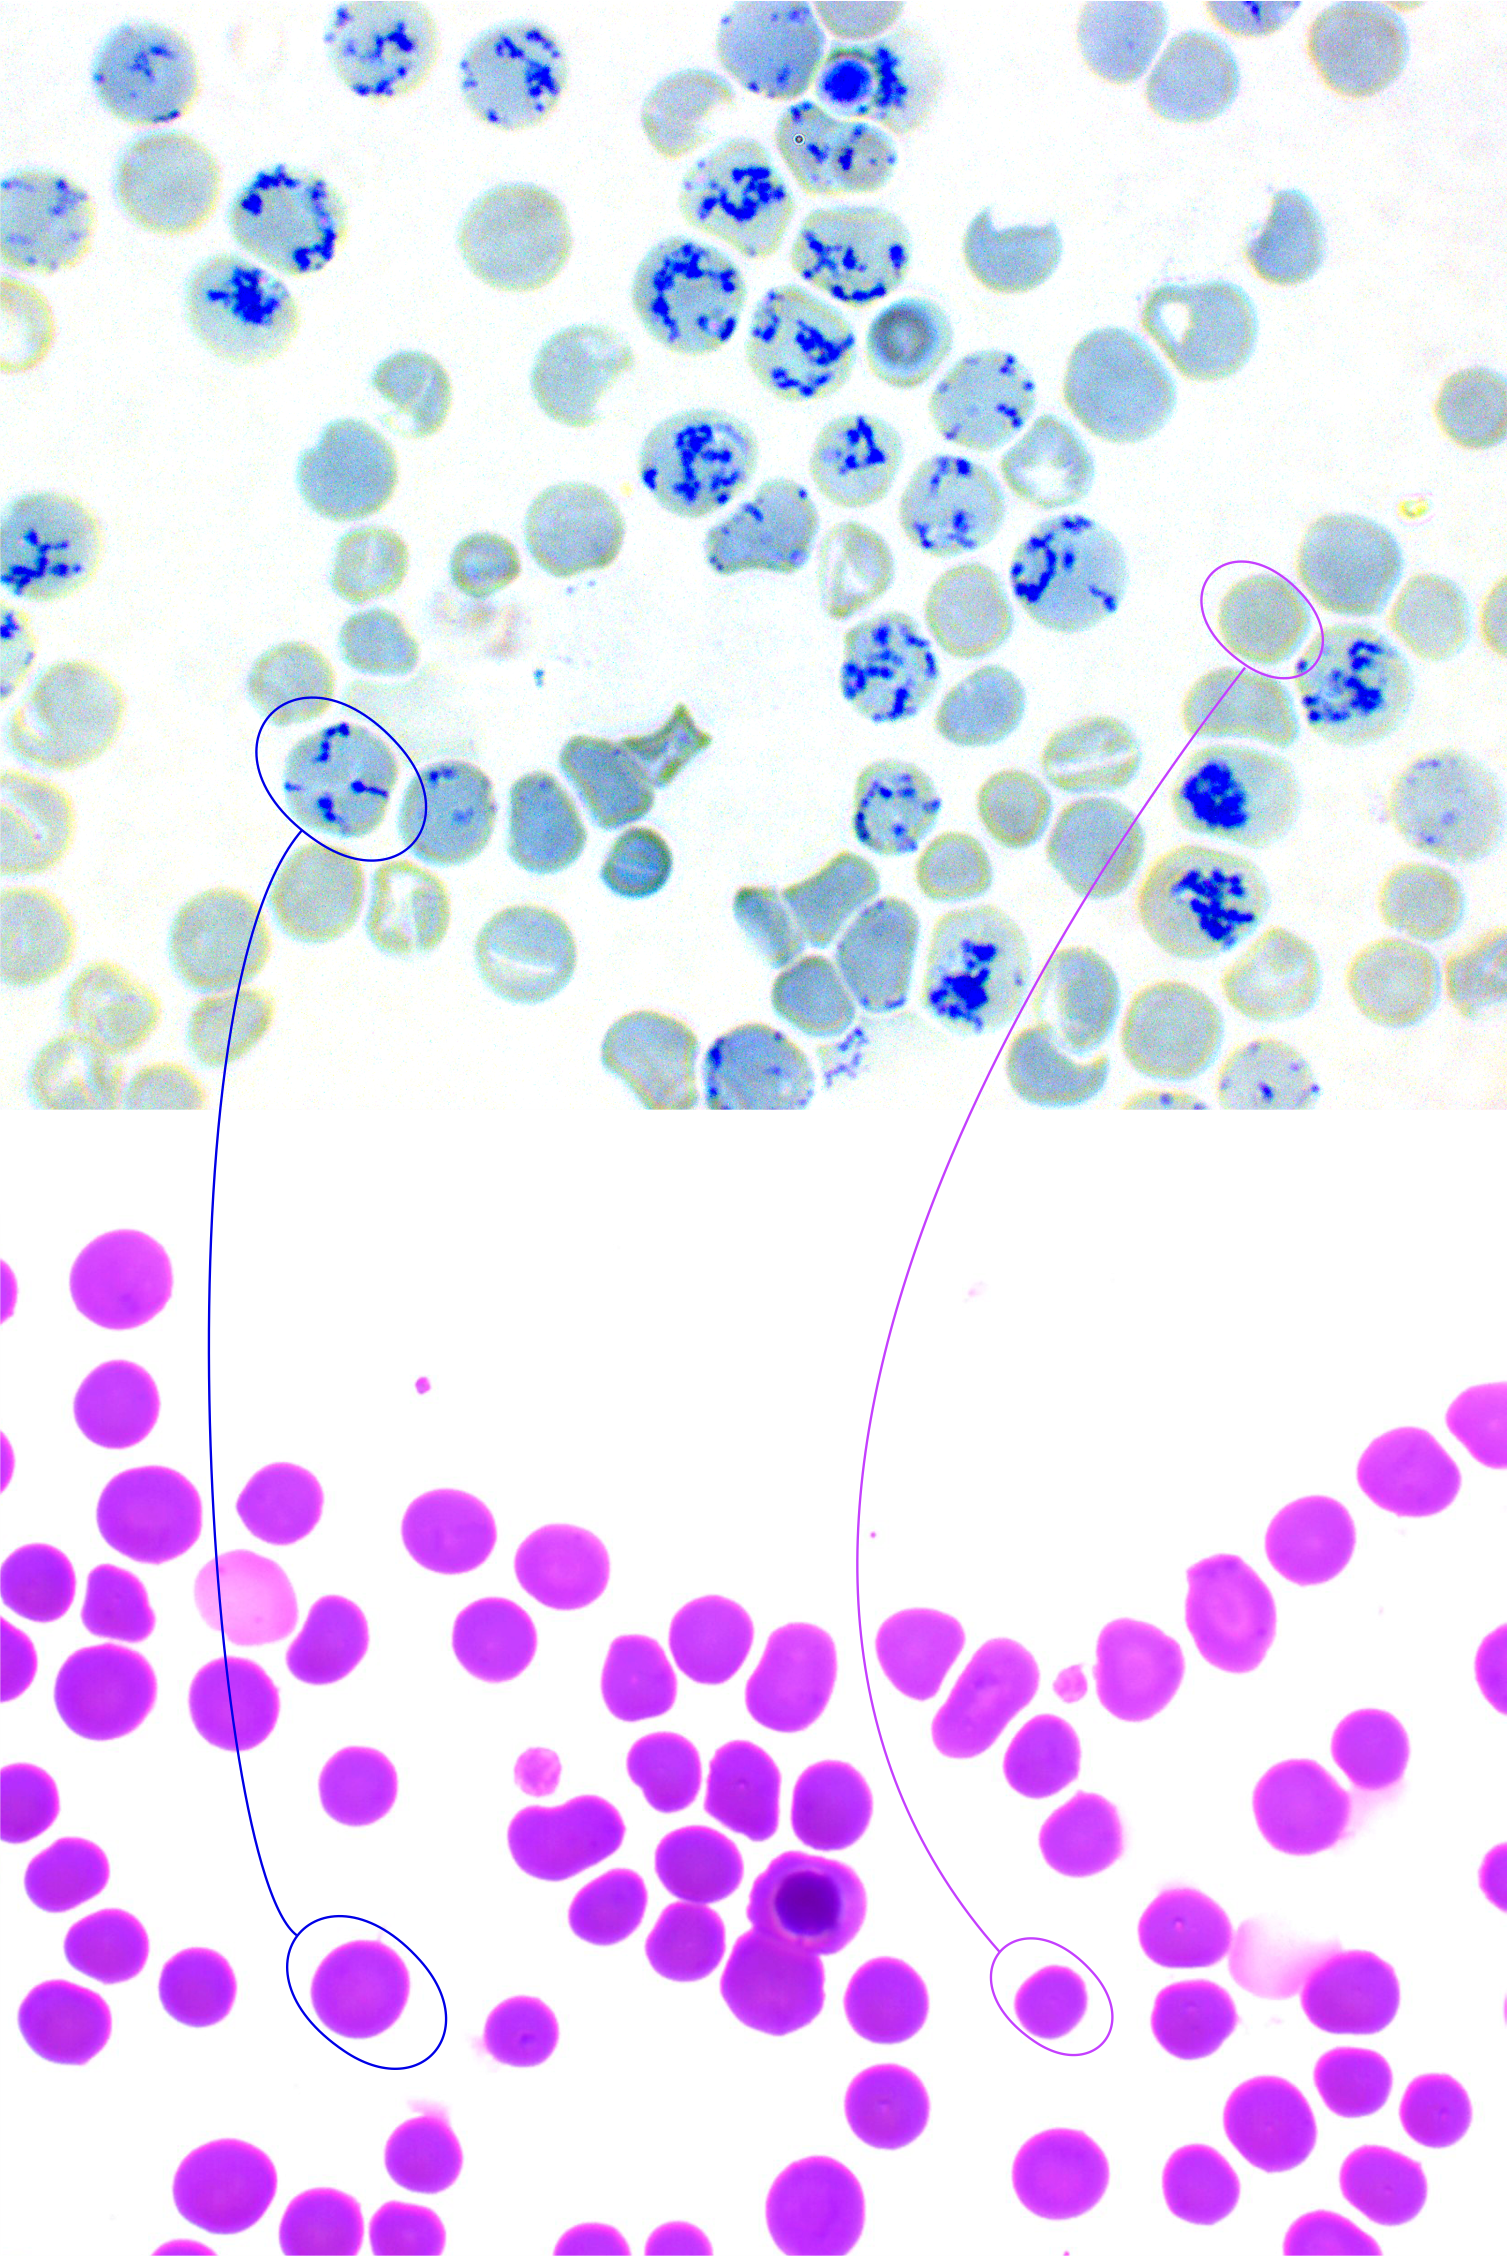
tinción vital nuevo azul de metileno

Anemia regenerativa tinción vital
Los reticulocitos son eritrocitos inmaduros presentes en sangre periférica, lugar donde terminan su maduración a hematíes. Contienen restos de ARN y ribosomas que precipitan en presencia de los coloranes vitales como el azul de metileno.
Para la realización de la tinción se mezclan a partes iguales 2 ó 3 gotas de colorante nuevo azul de metileno con sangre entera, a continuación se mezcla suavemente para evitar la lisis de los hematíes. La mezcla se deja en reposo durante unos 15 minutos a temperatura ambiente, para luego, realizar una extensión sanguínea sobre un portaobjetos. La extensión se observa al microscopio óptico con objetivo de inmersión.
Los reticulocitos se identifican fácilmente por la presencia en su interior de un punteado azul oscuro que se corresponde con restos de ARN y Ribosomas.
En el centro de la preparación teñida con diff Quick (foto inferior) puede observarse una célula roja nucleada.